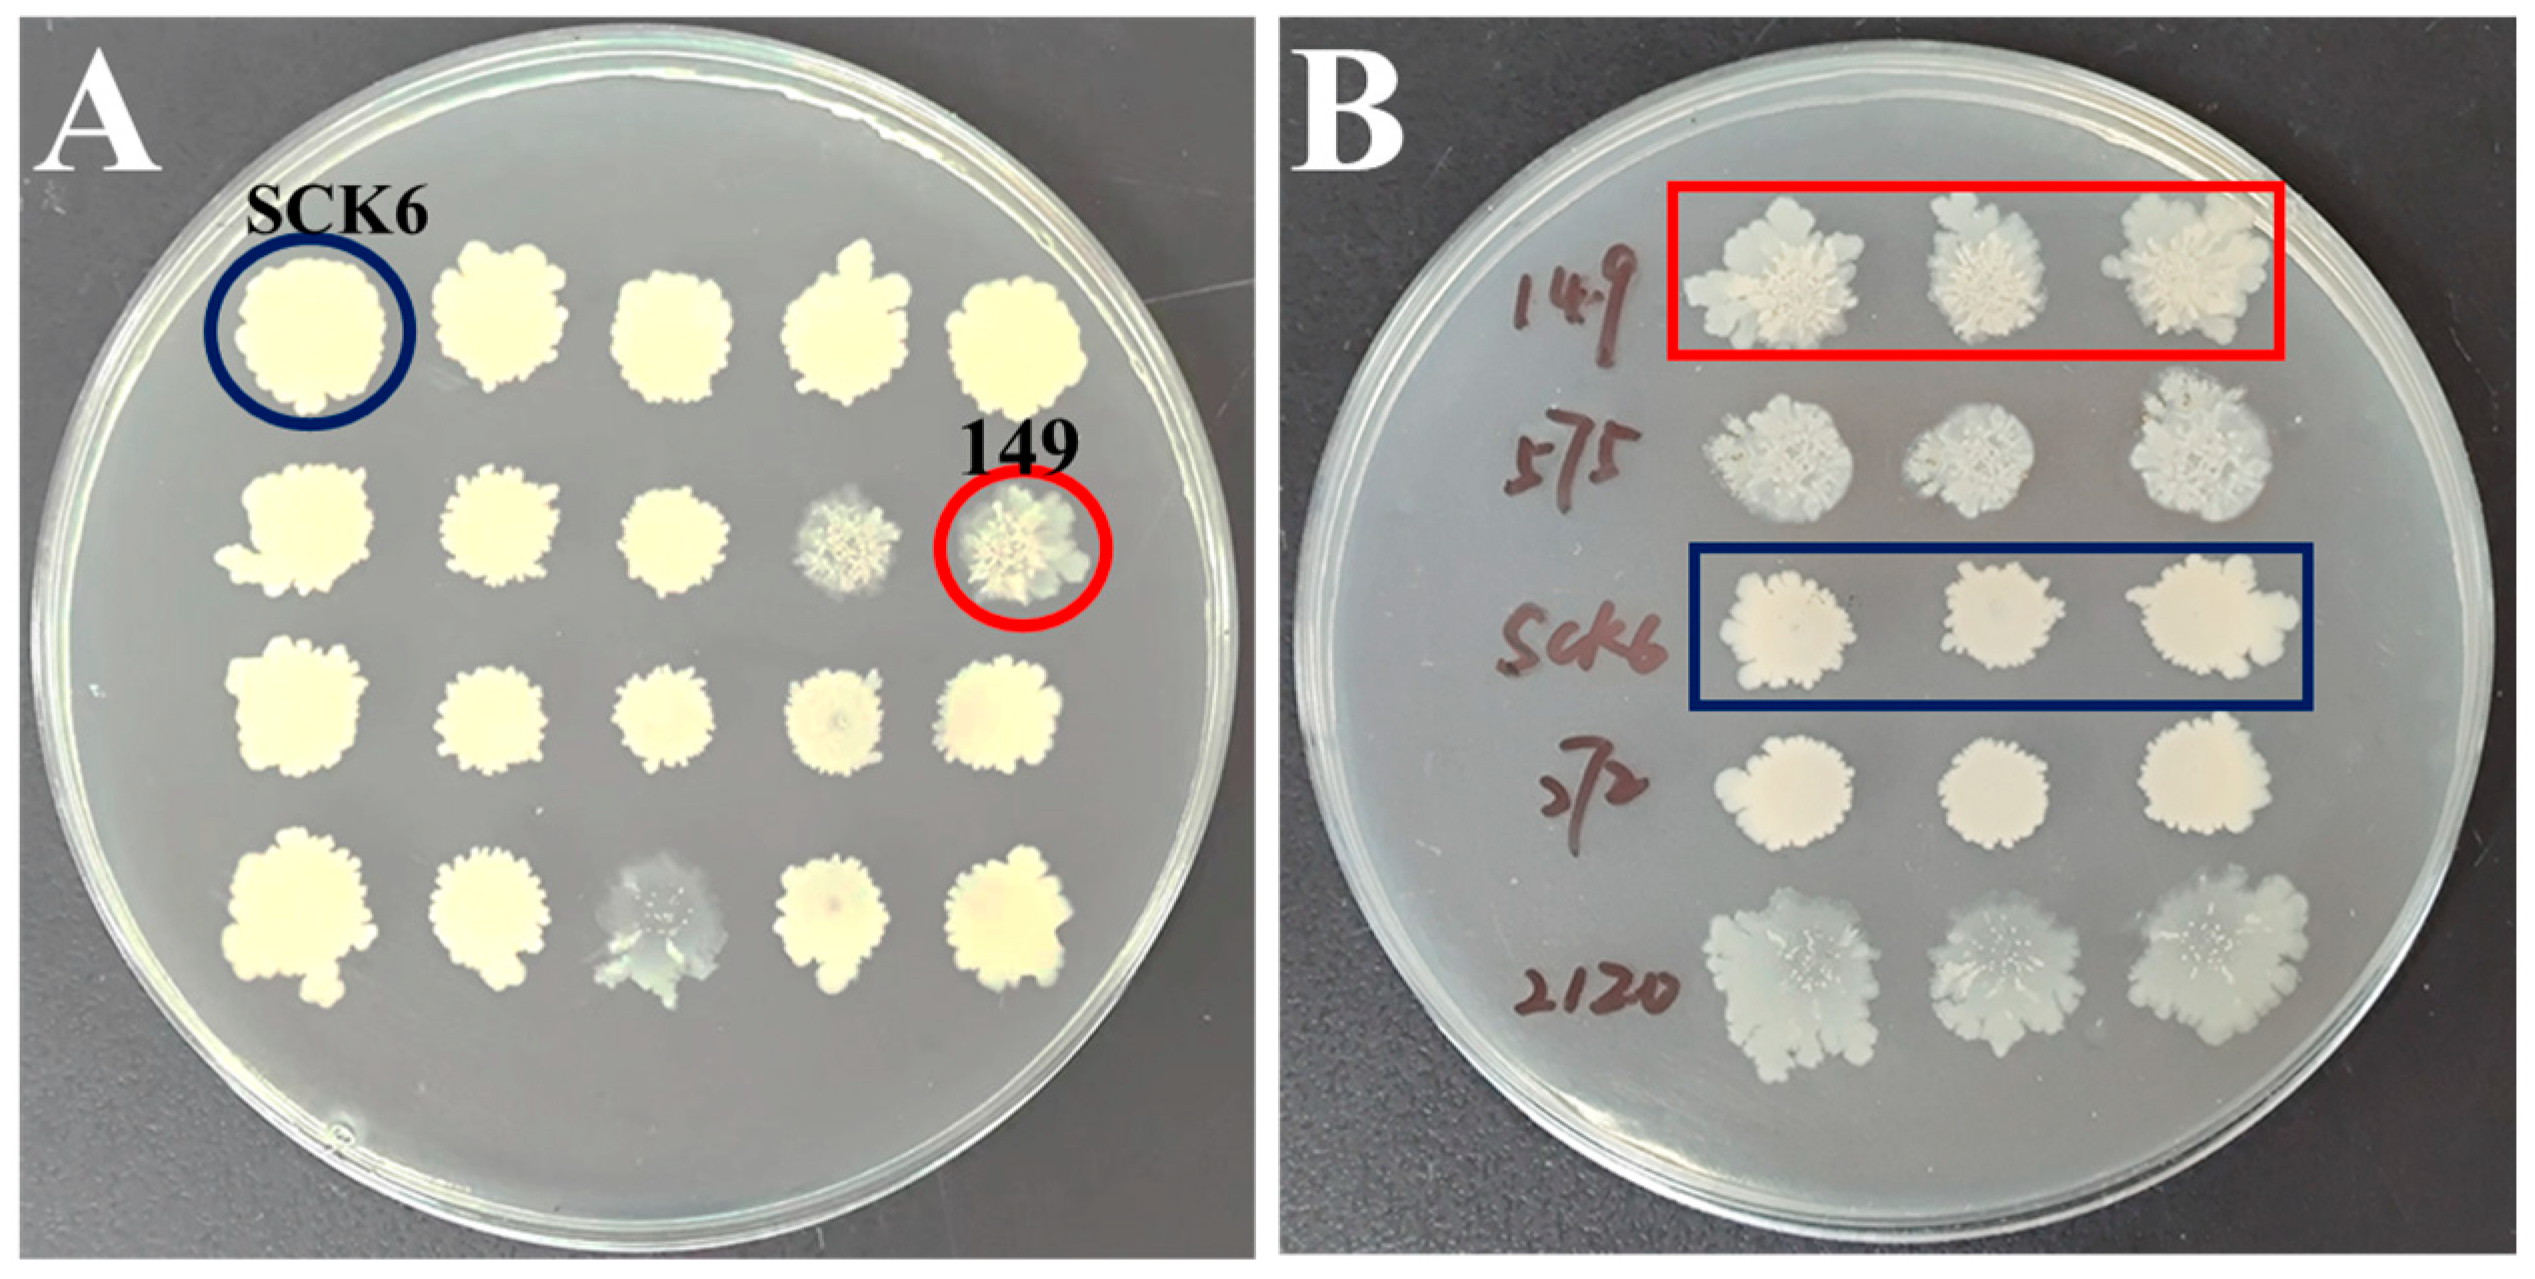
Fishes 10 00109 g001

Abstract
Antimicrobial peptides (AMPs) are biocompatible and biodegradable, making them an attractive alternative to traditional antimicrobial agents and chemical preservatives. Here, a novel α-helix amphiphilic anionic AMP Lc149 was screened from a large yellow croaker (Larimichthys crocea) using a Bacillus subtilis expression system. Lc149 is a hypothesized protein fragment not annotated in the genome of a large yellow croaker. Both extracellular protein and recombinant Lc149 (rLc149) exhibited significant killing effects against Gram-negative Escherichia coli and Vibrio harveyi. Scanning and transmission electron microscopy revealed that rLc149 had the ability to disrupt bacterial cell membranes, causing irregular cell morphology, severe cell membrane damage, cytoplasm agglutination, and intracellular content leakage. Confocal laser scanning microscopy and flow cytometry further confirmed bacterial cell destruction and mortality rates of over 80%. Gel retardation assays and SDS-PAGE electrophoresis showed that rLc149 was unable to bind to bacterial DNA, but did reduce bacterial protein contents. Additionally, rLc149 maintained antibacterial activity against E. coli and V. harveyi upon exposure to temperatures of 25–100 °C, UV radiation time of 0–60 min, pH levels of 3–12, and different proteases. Biosafety assays revealed low hemolytic toxicity to erythrocytes of large yellow croaker, rabbit, and shrimp, and low cytotoxicity to large yellow croaker kidney cells and HEK 293T cells. More deeply, rLc149 also possessed significant killing activity against parasites. Therefore, rLc149 can be considered an antibacterial and antiparasitic drug in fisheries.
Key Contribution:
In this study, a new antimicrobial peptide, Lc149, was found to have an obvious antibacterial effect on fish pathogens (E. coli and V. harveyi) and a killing effect on fish parasites. In addition, rLc149 is low in hemolysis, safety, and stability. The antimicrobial peptide Lc149 can be used in the aquaculture industry to treat and prevent infections in fish.
1. Introduction
With the continuous expansion of aquaculture production and the increasing density of farming operations, the aquaculture industry is encountering a series of significant challenges [1,2,3,4]. These include the degradation of germplasm resources, destruction of marine environments, and a growing prevalence of disease outbreaks. Furthermore, variations in climate conditions and water quality across different regions exacerbate the farming environment [5,6], leading to frequent disease occurrences caused by bacteria, viruses, and parasites [7]. These issues pose serious threats to the healthy and sustainable development of the aquaculture industry [8,9].
Compared to traditional antibiotics, antimicrobial peptides (AMPs) are naturally occurring molecules found in animals, plants, and microorganisms [10]. They offer distinct advantages, including low potential for drug resistance and minimal toxicity to the host. AMPs can effectively inhibit a wide range of pathogens, such as bacteria, fungi, viruses, parasites, and even tumor cells, making them an ideal alternative to traditional antibiotics and a promising solution to combat “superbugs”. In fish, AMPs serve as a crucial first line of defense against various pathogens and play an integral role in the innate immune system of bony fish [11,12].
Bacillus subtilis, a Gram-positive bacterium, has been extensively studied due to its favorable characteristics, including a short fermentation cycle, non-pathogenicity, and efficient secretion mechanism, and has been recognized as a Generally Recognized As Safe (GRAS) strain by the Food and Drug Administration [13]. Moreover, the B. subtilis expression system has the advantage of easy operation, high efficiency, and safety due to its small genome and amenability to genetic engineering, and can be used for protein expression and purification [14]. In recent years, technical improvements have been made to the B. subtilis expression system, such as using high cell density culture and metabolic engineering methods to enhance expression level and purification efficiency [15]. In summary, the B. subtilis expression system makes large-scale production of AMPs possible [16].
In this study, a novel AMP, named Lc149, was identified from a large yellow croaker (Larimichthys crocea). Lc149, as a hypothetical protein fragment, was subjected to biological information analysis. The antibacterial mechanism of Lc149 was further investigated using scanning electron microscopy, transmission electron microscopy, SDS-PAGE, gel blocking, SYTO9/PI staining, confocal laser microscopy, and flow cytometry. In addition, significant parasite-killing activity was presented. Finally, the stability and safety of this AMP were evaluated.
2. Materials and Methods
2.1. Ethics
The experimental fish were anesthetized with tricaine methane sulfonate (MS-222; Sigma, St. Louis, MO, USA) for sample collection and anatomical observation in accordance with the protocols (Number: Jmu20240830) approved by the Animal Care and Use Committee at the College of Aquaculture, Jimei University. The remaining surviving fish were euthanized using MS-222.
2.2. Sample Collection
Healthy large yellow croaker (~10 g) cultured in the Ningde Sea, China. Before the experiment, an appropriate amount of L. crocea was cultured in a sea tank with filtration and aeration at 25 °C and fed twice a day. Pseudomonas plecoglossicida was cultured to infect L. crocea during logarithmic growth at 30 °C. Healthy L. crocea was infected with P. plecoglossicida at a final concentration of 1 × 106 CFU/mL for 3 h and then transferred to a new clean pool. Tissue samples (spleen, liver, kidney) of the above L. crocea infected with bacteria were collected 24 h, 48 h, and 72 h after infection and stored at −80 °C for subsequent RNA extraction.
2.3. Construction of B. subtilis Engineered Strain
Total RNA was extracted from collected samples using the Trizol kit (Invitrogen, Waltham, MA, USA) and purified using the PolyATtract® mRNA separation system (Promega, Madison, WI, USA). A cDNA library was constructed using the PrimeScript™ Double Strand cDNA Synthesis Kit (TaKaRa, Beijing, China). The cDNA library was ligated with Xba I and Nde I cleavage sites. The pBE-S plasmid was linearized by Xba I and Nde I restriction enzymes and ligated with the cDNA library. The recombinant plasmid was transformed into B. subtilis SCK6 receptor cells. The quality of the cDNA library was assessed by colony PCR using pBE-SF/R primers for each transformant.
2.4. Screening of Candidate Antibacterial Genes
All the transformants in the constructed cDNA library were sampled on Luria–Bertani (LB) plates containing kanamycin (10 mg/L) and incubated at 37 °C for 72 h to observe the phenotypes. The strains that showed autolyzation were considered to have successfully inserted large yellow croaker sequence fragments into the B. subtilis system. Then, the stable autolysis of the strain was verified by using three repeated point plates. The characterization of B. subtilis SCK6 unloaded strain (no dissolution phenomenon) was used as a control. The above stable autolysis strains were sequenced (Tsingke, Xiamen, China).
2.5. Extracellular Protein Acquisition
B. subtilis is an important protein-secreting host with high extracellular protein secretion capacity. B. subtilis 149, which exhibits stable autolysis, was cultured in a liquid LB medium (10 mg/L kanamycin), and protein was extracted using ammonium sulfate precipitation. After being cultured at 37 °C for 72 h, the supernatant of B. subtilis 149 was collected by centrifugation at 8000 r/min for 10 min. The protein was salted out from the supernatant using saturated ammonium sulfate. The salt-out substance was collected by centrifugation at 4 °C at 10,000 r/min for 30 min and then dissolved in 25 mM PBS Buffer (pH 7.0). To purify the salt, the solution was placed in PBS buffer at 4 °C for 24 h, during which the buffer was changed every 4 h.
2.6. Antibacterial Experiment of Extracellular Protein
The antibacterial activity of the extracellular protein was analyzed using the agar diffusion method. The indicator bacteria Escherichia coli and Vibrio harveyi with 500 μL concentration of 1 × 108 CFU/mL were mixed with 5 mL semi-solid medium and poured onto a solidified 10 mL lower LB plate, respectively. Then, a 6 mm diameter hole punch was used to drill holes, and 50 μL of extracellular protein (1000 μg/mL) was added to each hole to detect the antibacterial activity of the extracellular protein. The antibacterial activity was reflected by the diameter of inhibition zone (DIZs). Extracellular protein secreted by B. subtilis SCK6 was used as a control.
2.7. Expression and Purification of Recombinant Antimicrobial Peptides
The pET32a plasmid was digested with EcoR I and Xho I restriction enzymes, and the linearized plasmid was linked to the Lc149 gene to form the pET32a-Lc149 recombinant plasmid (rLc149). The Lc149 gene sequence was obtained based on previous sequencing of B. subtilis 149. To clone the sequence, we designed a pair of specific primers (rLc149-F and rLc149-R, Table 1) with EcoR I and Xho I restriction sites, following the protocol of the ClonExpress® II One Step Cloning Kit (Vazyme, Nanjing, China). PCR program settings of Lc149 gene sequence: an initial denaturation step at 95 °C for 3 min, followed by 35 cycles of 95 °C for 15 s, 50 °C for 15 s, and 72 °C for 2 min, and a final extension step at 72 °C for 5 min. PCR program settings of pET32a-Lc149 recombinant plasmid: the digested plasmid and Lc149 gene sequence were maintained at 37 °C for 30 min. The recombinant plasmid was introduced into a Trelief 5α Chemically Competent Cell (Tsingke, Xiamen, China) using the heat shock method and then evenly spread onto an LB agar plate for inverted incubation at 37 °C for 12 h. After incubation, individual colonies were selected and screened to confirm the successful construction of the target sequence. Colonies with the correct sequence were preserved for subsequent experiments.
Table 1.
Primers in this study.
The plasmids pET32a-Lc149 and their parent vector pET32a (negative control) were transformed into E. coli BL21 (DE3) (Vazyme, Nanjing, China). The recombinant plasmid pET32a-Lc149 was cultured and induced for expression with a final concentration of 0.01 mM IPTG at 16 °C for 16 h. After centrifugation at 7000 r/min for 20 min, the bacteria were collected, resuspended in 20 mM imidazole buffer (pH 7.4), and subjected to ultrasonic crushing. The supernatant collected by centrifugation at 10,000 r/min for 20 min was loaded onto a Ni column, which had been balanced with 20 mM imidazole buffer (pH 7.4). The recombinant protein was loaded, and many other proteins were eluted with a 40 mM imidazole buffer (pH 7.4). The target proteins were finally eluted with 500 mM imidazole eluting buffer (pH 7.4). The purified protein was analyzed by 12% SDS-PAGE and desalted by dialysis with 0.01 M PBS buffer (pH 7.4).
2.8. Bioinformatics Tools Were Used to Analyze and Screen Antimicrobial Peptides
Homology analysis of Lc149 was performed using the NCBI online website (https://www.ncbi.nlm.nih.gov/, accessed on 10 February 2023). The molecular mass and isoelectric point of the protein were predicted on the EXPASY server (https://www.expasy.org/, accessed on 22 April 2024). The secondary structure of the protein was predicted using the Phyre2 online website (https://www.sbg.bio.ic.ac.uk/phyre2/html/, accessed on 25 April 2024) and the 3D model was constructed using the Vector NTI Suite 8 with mutual verification performed using circular dichroism (CD).
The secondary structure of the protein was analyzed by CD spectroscopy. The protein was dissolved in 0.2 M PBS Buffer (pH 7.3) to a final concentration of 1.0 mg/mL. A 1 mm quartz cuvette was used for the measurement. The scan speed was 100 nm/min, and the data was recorded at 1.0 nm intervals. The formula is [θ] = medg × M/ (10 × c × nr), where medg is the value of CD, M is the molar mass of the peptide, c is the concentration of the peptide, and nr is the amino acid residue base.
2.9. Analysis of Antibacterial Activity of rLc149
2.9.1. Antibacterial Activity Assay by Agar Diffusion Method
This experimental method was consistent with the antibacterial activity analysis of the extracellular protein. A 50 μL addition of rLc149 (1000 μg/mL) was used to detect antibacterial activity against E. coli and V. harveyi, with the antibacterial activity reflected by DIZs (mm). The protein expressed by the empty carrier pET32a was used as a control.
2.9.2. MIC and MBC Detection
The MIC of rLc149 was determined using the double dilution method in a 96-well plate. The final protein concentration of rLc149 was adjusted to 1000, 500, 250, 125, 62.5, 31.25, and 15.625 μg/mL. The negative control hole was added with an equal volume of 0.01 M PBS buffer (pH 7.4). After 24 h of incubation, the gradient concentration at which the indicator bacteria could not grow was identified as the MIC of rLc149. The culture bacterial solution was visually observed, showing no bacterial growth, and coated onto a solid culture medium. After incubation for 24 h, the corresponding antimicrobial peptide concentration without bacterial growth is MBC.
2.9.3. Bactericidal Kinetics Curve
E. coli and V. harveyi cultured to the logarithmic growth phase were mixed with rLc149 at gradient concentrations (0.5 × MIC, 1.0 × MIC, 2.0 × MIC, 4.0 × MIC, and 8.0 × MIC) and incubated at 37 °C and 30 °C, respectively. The final concentration of indicator bacteria was OD600 = 0.1. The turbidity OD600 of the cultures was measured every hour over a 24 h period using a FlexA-200 Microplate Reader (Hangzhou, China). Bacteria without rLc149 treatment served as the negative control.
2.10. Antibacterial Mechanism Analysis
2.10.1. Scanning Electron Microscopy (SEM) Analysis
The bacteria in the logarithmic growth stage were collected, washed three times with PBS buffer, and adjusted to an OD600 of 1.0. rLc149 (50 μL, 500 μg/mL) was mixed with the bacteria in equal volume and incubated for 2 h. The sample was fixed at 4 °C for 3 h with 2.5% glutaraldehyde aqueous solution, dehydrated in a series of ethanol solutions (50%, 70%, 90%, 95%, 100%), and dried overnight at 55 °C. It was then observed by SEM (Hitachi S-4800, Japan).
2.10.2. Transmission Electron Microscopy (TEM) Analysis
The sample was prepared according to the co-incubation method of rLc149 with bacteria in SEM. Then, 20 μL of the incubated bacterial sample was added to the copper mesh, negatively stained with tungsten phosphate solution, and imaged on an H-7650 TEM.
2.10.3. Confocal Laser Scanning Microscope (CLSM) Analysis
Bacterial viability was assessed using the Live/Dead BacLight™ Bacterial Viability Kit (Invitrogen, thermofisher scientific, Shanghai, China). When SYTO9 and Propidium Iodide (PI) were used simultaneously, PI, with its stronger nucleic acid binding affinity, displaced SYTO9 bound to the nucleic acids of dead cells, causing them to emit red fluorescence. In contrast, live cells retain SYTO9 and exhibit green fluorescence. This allows for the clear differentiation of live (green) and dead (red) bacteria using confocal microscopy. A bacterial suspension (OD600 = 1.0) was mixed with rLc149 at a final concentration of 500 μg/mL, resulting in a total volume of 200 μL. The mixture was incubated for 2 h, followed by the addition of 50 μL of the Live/Dead BacLight™ staining solution. After staining for 15 min, the samples were observed and imaged using a confocal laser scanning microscope (CLSM, Leica SP8). The control group was treated with the purified Trx-His-tag protein expressed using the pET32a vector instead of rLc149.
2.10.4. Flow Cytometry Analysis
PI is a red fluorescent nucleic acid dye widely used for detecting cell death. Since PI can only penetrate cells with compromised membranes, it binds to double-stranded DNA and emits red fluorescence. In flow cytometry, cell viability is assessed by measuring PI uptake and analyzing SSC-A/PE-A scatterplots to identify cell populations that have internalized fluorescently labeled particles. A mixture of 500 μg/mL rLc149 and 200 μL of indicator bacteria (OD600 = 1.0) was prepared, thoroughly mixed, and incubated for 6 h. PI dye was then added to a final concentration of 40 μg/mL, followed by incubation at 4 °C in the dark for 20 min. Finally, cell mortality was evaluated using a flow cytometer (Beckman, Brea, CA, USA).
2.10.5. Gel Retardation Analysis
AMPs can bind with pathogenic bacterial nucleic acids to form nucleic acid–protein complexes, which can degrade bacterial nucleic acid structure. To explore the intracellular targeting mechanism, we determined the DNA binding affinity of rLc149 using a gel retardation assay. The electrophoretic mobility of DNA bands at various peptide concentrations of the peptide was analyzed on an agarose gel. Bacterial DNA was extracted using a FastPure® Bacteria DNA Isolation Mini Kit (Vazyme, China). After incubation with different concentrations of rLc149 (0.5 × MIC, 1.0 × MIC, 2.0 × MIC, 4.0 × MIC, 8.0 × MIC) at room temperature for 1 h, DNA integrity was analyzed by 1% gel electrophoresis.
2.10.6. Bacterial Protein Content Analysis
The indicator bacteria of OD600 = 1.0 were incubated with rLc149 (0.5 × MIC, 1.0 × MIC, 2.0 × MIC, 4.0 × MIC, 8.0 × MIC) of different concentrations at 37 °C/30 °C for 12 h. The bacteria were centrifuged at 10,000 r/min to obtain the precipitate. Bacterial protein was extracted according to the bacterial protein extraction kit instructions. The protein content was detected by 12% SDS-PAGE electrophoresis (Vazyme, China) and a BCA protein quantification kit (Lablead, Beijing, China).
2.11. rLc149 Activity Against Parasite
The scuticociliatida was cultured in a petri dish with sterilized seawater at 16 °C. Approximately 300 ciliates were added to a 48-well (total volume 1.5 mL) containing a final concentration of 500 μg/mL rLc149 and incubated at 16 °C. The ciliates were observed by optical microscope at 30 min, 1 h, and 2 h. Under the same conditions, the purified Trx-His-tag protein expressed using the pET32a vector was used as a control.
2.12. Stability Assay
The stability of rLc149 was evaluated under various conditions as previously described [17]. Heat resistance was assessed by treating rLc149 protein with a temperature gradient (25 °C, 50 °C, 75 °C, 100 °C) for 30 min. Acid and alkaline resistance was tested by exposing the protein to pH 3.0, 5.0, 7.0, 9.0, and 11.0 for 30 min. Radiation resistance was evaluated by UV irradiation for 0, 15, 30, 45, and 60 min. Finally, enzymatic hydrolysis by lipase (30 °C), α-amylase (55 °C), pepsin (37 °C), and trypsin (37 °C) were used to investigate protease effects on rLc149. The agar diffusion method was used to determine the antibacterial activity of rLc149 after treatment with various conditions.
2.13. Hemolytic Analysis
The live large yellow croaker, shrimp, and rabbit were purchased from a food market and anesthetized, and their blood samples were collected by the authors, specifically from the fish vein, shrimp pericardial cavity, and rabbit marginal ear vein. The blood samples were centrifuged and washed three times with TBS buffer (0.2 M, pH 7.2) to isolate erythrocytes. The erythrocytes were resuspended in TBS buffer and mixed with different concentrations of protein solutions (0, 15.625, 31.25, 62.5, 125, 250, 500, 1000 µg/mL) in equal volumes. TBS buffer served as a negative control (no hemolysis), and double-distilled water represented 100% hemolysis. The hemolytic percentage was calculated using the equation: Hemolysis (%) = [(test group A540 − negative control group A540)/(positive control group A540 − negative control group A540)] × 100%.
2.14. Cytotoxic Analysis
Cytotoxic analysis of rLc149 was evaluated using the CCK8 assay (Labeled, China) to assess its effects on the kidney cells of large yellow croaker (LYCPCK cells) and HEK 293T cells. LYCPCK cells and HEK 293T cells were cultured in Minimum Essential Medium (MEM) and Dulbecco modified Eagle medium (DMEM), respectively, supplemented with 10% fetal bovine serum (FBS), and incubated at 37 °C in a 5% CO2 atmosphere. Cells were seeded in a 96-well plate at 1.5 × 104 cells/well and grown until 80% confluence. Different concentrations of rLc149 were added to each well, with final concentrations of 15.625, 31.25, 62.50, 125.0, 250.0, 500, and 1000 μg/mL. After 24 h incubation at 37 °C in a 5% CO2 atmosphere, 10 μL CCK8 solution was added to each well and incubated in the dark for 1–4 h. Absorbance was measured at 450 nm. Control wells contained CCK8 and cells without rLc149, while blank wells contained CCK8 and medium without cells.
2.15. Statistical Analysis
All experiments were repeated thrice, and data were expressed as mean ± standard error. One-way ANOVA, LSD multiple comparison, and an independent sample T-test were used for statistical analysis in SPSS 20.0. A p < 0.05 indicated statistically significant differences between groups.
3. Results
3.1. Construction of B. subtilis Engineered Strain 149
To search for more AMPs, a large yellow croaker cDNA library was constructed and transferred to B. subtilis SCK6 receptor cells. B. subtilis 149 showed a self-dissolution phenomenon after 72 h culture (Figure 1A). Repetition three times verified B. subtilis 149 had stable autolysis, suggesting that an AMP was inserted (Figure 1B). Second-generation sequencing yielded the sequence of strain 149. A hypothesized protein fragment was found inserted into B. subtilis 149. This protein function has not been introduced or studied.
Figure 1.
Construction of the B. subtilis 149 strain. (A): B. subtilis 149 showed lysis phenotype after insertion of large yellow croak cDNA library; (B): repeat sampling 3 times, B. subtilis 149 showed stable autolysis phenomenon. Blue and red graphic labels indicate B. subtilis SCK6 (negative control) and B. subtilis 149, respectively. The numbers 149, 575, 272, and 2120 only represent the labels used in the screening of autolytic strains. In this paper, strain 149 was used for functional study.
3.2. Antibacterial Activity Analysis of Extracellular Protein
B. subtilis has a secretion system that allows B. subtilis 149 to directly secrete extracellular protein. The extracellular protein showed good antibacterial effects against E. coli and V. harveyi, with antibacterial diameters of 15.5 ± 0.90 mm and 11.00 ± 0.10 mm, respectively (Figure 2, Table 2). In contrast, the extracellular protein of B. subtilis SCK6 had no antibacterial effect against the indicator bacteria in the control group.
Figure 2.
Extracellular protein secreted by B. subtilis 149 had antibacterial activity against E. coli (A) and V. harveyi (B). CG: control group, B. subtilis SCK6 extracellular protein; TG: test group, extracellular protein of 149 strains.
Table 2.
Diameters of Inhibition zone (DIZs) of B. subtilis 149 extracellular proteins against diverse bacteria.
3.3. Characterization of the Lc149 Structure
To validate the antibacterial function of this hypothesized protein fragment, the peptide rLc149 was successfully expressed using the pET32a vector. The rLc149 protein was detected at approximately 27 kDa by SDS-PAGE, corresponding to the predicted molecular mass of 20 kDa + 7.54 kDa (Figure 3). CD spectra analysis showed a positive peak at 192 nm and two negative peaks at 208 nm and 220 nm, indicating an α-helix structure, consistent with the predicted structure using the Phyre2 online website (Figure 4A,B).
Figure 3.
Expression and purification of Lc149 protein. Lane M: Protein marker; Lane 1–2: pET32a empty vector protein expression without and with IPTG, respectively; Lane 3–4: pET32a-Lc149 recombinant protein expression without and with IPTG, respectively; Lane 5–6: supernatant and precipitation of pET32a-Lc149 recombinant protein expression, respectively; Lane 7–8: pET32a empty vector protein and pET32a-Lc149 recombinant protein purified by affinity column, respectively.
Figure 4.
Peptide structure analysis. (A) The tertiary structure of Lc149 was predicted using the online website Phyre2; (B) rLc149 was determined using circular dichroic spectroscope. Purple, blue, and gray represent α-helix, β-strand, and random coil, respectively.
Protein sequence alignment showed that Lc149 (GenBank accession number: OR262350) is a hypothesized protein fragment that is not annotated in the genome of large yellow croaker. Furthermore, Lc149 has an isoelectric point of 4.35 and a net charge of −8.25. Consequently, Lc149 is a novel amphiphilic, α-helix, and anionic AMP.
3.4. Antibacterial Activity Monitoring of rLc149
rLc149 had inhibitory effects against E. coli (Figure 5A) and V. harveyi (Figure 5B) at a concentration of 500 μg/mL (50 μL), with inhibitory diameters of 12.83 ± 0.58 mm and 10.17 ± 0.29 mm, respectively (Table 3). The MIC of E. coli and V. harveyi was 31.25 μg/mL and 62.5 μg/mL, respectively, and the MBC of both was 62.5 μg/mL each (Table 3). Next, the growth curve of two indicator bacteria was monitored for 24 h (Figure 6). Results showed both indicator bacteria showed similar growth changes in the presence of rLc149 treatment. At 0.5 × MIC, the growth of indicator bacteria in the experimental group was similar to the control group, regardless of E. coli (Figure 6A) or V. harveyi (Figure 6B), but was relatively inhibited in the case of V. harveyi. Overall bacterial growth was only slightly inhibited. When the concentration of rLc149 was 8.0 × MIC, the indicator bacteria were severely inhibited compared to the control group, with V. harveyi ’s growth curve being particularly significant. Taken together, these results suggest that a hypothesized protein from a large yellow croaker (rLc149), AMP, possesses antibacterial activity against E. coli and V. harveyi.
Figure 5.
Antimicrobial activity analysis of rLc149 against E. coli (A) and V. harveyi (B), CG: control group, pET32a no-load protein; TG: test group, pET32a-Lc149 recombinant protein.
Table 3.
Diameters of Inhibition zone (DIZs), MIC, and MBC of rLc149 against E. coli and V. harveyi.
Figure 6.
The growth curve of E. coli (A) and V. harveyi (B) with rLc149 treatment.
3.5. Analysis of the Antibacterial Mechanism of Lc149
3.5.1. Disruption of Bacterial Structures
AMPs primarily eliminate bacteria by binding to cell membranes or cell walls, creating pores that cause leakage of cell contents and bacterial death. In this study, untreated E. coli (Figure 7A) and V. harveyi (Figure 7C) showed normal morphology with distinct cell boundaries under SEM. After treatment with rLc149, E. coli (Figure 7B) and V. harveyi (Figure 7D) exhibited significant morphological changes. E. coli was severely deformed and had damaged cell walls, while V. harveyi showed cell membrane rupture and a concave appearance. TEM images revealed a high electron density inside E. coli, indicating cytoplasmic agglutination, cell membrane breaches, and contents leakage compared to the control (Figure 8A,B). Similarly, V. harveyi showed cell membrane disintegration and cytoplasmic effusion (Figure 8C,D).
Figure 7.
The damage of rLc149 to indicator bacteria was observed using scanning electron microscopy. (A,C) indicated the effect of pET32a no-load protein on E. coli and V. harveyi, respectively. (B,D) represent the effects of rLc149 on E. coli and V. harveyi, respectively. The scale is 1.0 μm. The box indicates that the bacterial cell membrane is completely broken, and the arrows indicate that the bacteria was deformed and had pores.
Figure 8.
E. coli and V. harveyi after rLc149 treatment were observed using transmission electron microscopy. (A,C) indicate the effect of pET32a no-load protein on E. coli and V. harveyi, respectively. (B,D) represented the effects of rLc149 recombinant protein on E. coli and V. harveyi, respectively. Scale: 0.2 μm for E. coli group and 0.5 μm for V. harveyi group. The box shows the leakage of bacterial contents and the aggregation of bacterial cytoplasm, and the arrow shows the change of bacterial cell morphology and structure.
3.5.2. Inhibition of the Bacterial Biofilm Formation
Outer membranes play an important role as a drug barrier in bacteria. To further investigate the damage degree of rLc149 on bacterial cell membranes, CLSM was used to observe live and dead bacteria. E. coli and V. harveyi were stained with SYTO9 and PI and then analyzed by CLSM (Figure 9). No red fluorescence was detected in the control group (pET32a protein treatment). In contrast, in the test group, the indicator bacteria were dyed by PI, accounting for most of the green fluorescence part of SYTO9, almost all, indicating that a large number of bacteria had been killed after rLc149 treatment. The results corresponded to those of flow cytometry experiments, in which the mortality ratio of the two indicator bacteria increased significantly compared to the control group, and the mortality rate of E. coli increased from 15.21% to 85.29% (Figure 10A,B). The bacterial mortality rate of V. harveyi increased from 10.01% to 89.66% (Figure 10C,D), indicating that rLc149 had destructive effects on bacterial cell walls and membranes.
Figure 9.
The effects of rLc149 on bacterial cell permeability of E. coli and V. harveyi were observed using confocal microscopy. The SYTO 9 (green) group represented all the bacteria within the visual field, while the PI (red) group specifically indicated the dead bacteria within the same visual field. Scale: 5 μm.
Figure 10.
The degree of damage caused by rLc149 to bacterial cell membranes using flow cytometry. (A,C): the control groups, E. coli and V. harveyi, were treated with pET32a vector protein, respectively. (B,D): E. coli and V. harveyi were treated with rLc149, respectively. The x-axis represents the relative fluorescence intensity, while the y-axis represents the side scatter light.
3.5.3. Inhibition of the Bacterial Protein Synthesis
As shown in Figure 11A,B, rLc149 failed to inhibit the migration of nucleic acids from both bacteria, i.e., was unable to bind with bacterial DNA to form a DNA–protein complex. Moreover, bacterial protein content was analyzed using SDS-PAGE electrophoresis and BCA protein quantification. As shown in Figure 12A–D, the protein concentrations of both indicator bacteria decreased with the increase of rLc149 protein concentration (Figure 12C,D), and the bands became lighter and lighter (Figure 12A,B), suggesting that rLc149 may inhibit bacterial protein synthesis, although cell membrane rupture could also contribute to decreased bacterial protein content.
Figure 11.
(A) (E. coli) and (B) (V. harveyi): Gel retardation assayed DNA binding affinity of rLc149. 1: ultra-pure water, 3–7: 0.5 × MIC, 1.0 × MIC, 2.0 × MIC, 4.0 × MIC, 8.0 × MIC of rLc149 protein.
Figure 12.
(A) (E. coli) and (B) (V. harveyi): SDS-PAGE electrophoresis analyzed bacterial protein content. 1: ultra-pure water, 3–7: 0.5 × MIC, 1.0 × MIC, 2.0 × MIC, 4.0 × MIC, 8.0 × MIC of rLc149 protein. (C) (E. coli) and (D) (V. harveyi): BCA kit determined the protein concentration. p < 0.05 * indicates differences between groups. n = 3.
3.6. A Significant Parasite Killing Activity of rLc149
Scuticociliatida is a facultative and saprophytic parasite that can live freely in water or inhabit live and dead fish [18]. This ciliate caused a large yellow croaker hemorrhage in the head, body anabrosis, and mass mortality, and aquatic products may also contain this parasite, although it does not transmit to humans. In this study, the ciliate displayed a clear sunflower seed structure with cilia and internal vacuoles in the control group (Figure 13A). After 30 min of treatment with rLc149, the ciliate body inflated, and partial cilia shedding occurred (Figure 13B). After 1 h, the parasite’s internal structure broke down, and the cilia completely disappeared (Figure 13C). After 2 h, scuticociliatida completely disintegrated (Figure 13D).
Figure 13.
The rLc149 has a significant parasite-killing activity. (A): the scuticociliatida in the control group without rLc149. (B–D): the scuticociliatida was incubated with rLc149 for 30 min, 1 h, and 2 h, respectively.
3.7. rLc149 Exhibits Relatively Stable Characteristics
In this study, after 30 min of high-temperature treatment (Figure 14A), UV irradiation (Figure 14B), and strong acidic and alkaline solution treatment (Figure 14C), rLc149 showed varying degrees of decreased antibacterial activity against both bacteria but still retained antibacterial activity under extreme conditions. In protease treatment (Figure 14D), rLc149 had some sensitivity and was relatively more sensitive to trypsin, but still retained good antibacterial activity.
Figure 14.
Antibacterial activity changes of rLc149 against E. coli and V. harveyi under different treatments. (A–D): temperature, ultraviolet irradiation, pH, and different protease treatments. n = 3. p < 0.05 is the significant difference indicated with letters (a, b, c) and an asterisk symbol (*).
3.8. Safety Assay
To evaluate the safety of rLc149, its hemolytic ratios and cytotoxicity were determined. As shown in Figure 15A,B, the hemolytic and cytotoxic effects of rLc149 were concentration-dependent. The hemolytic ratios of rLc149 on large yellow croaker, rabbit, and shrimp erythrocytes were 2.5%, 3.0%, and 3.0%, respectively, at 1.0 mg/mL of rLc149, with no observable hemolytic effects. The peptide at a concentration of 1.0 mg/mL did not induce significant toxicity to the host cells, with cytotoxicity of 6.07% and 9.35% on the kidney cells of large yellow croaker (LYCPCK) and HEK 293T cells, respectively.
Figure 15.
Hemolytic (A) and cytotoxic (B) effects of rLc149.
4. Discussion
The aquaculture industry is known as the fastest-growing food industry in the world, but its rapid expansion is accompanied by an astonishing increase in antibiotic use. In recent years, some antibiotic-resistant bacteria that infect humans may partially arise from aquatic products or aquaculture fish in the water environment. This indiscriminate use has contributed to the global challenge of antibiotic resistance, which the World Health Organization has identified as one of the top ten public health threats facing humanity. Furthermore, 15 drug-resistant bacteria have been highlighted as major concerns [2]. However, the target of AMPs on bacteria is not singular and lacks specificity, making it difficult for bacteria to develop resistance. Consequently, it is crucial to limit antibiotic usage and prioritize the development of green, safe, and effective alternatives.
In this study, a hypothesized protein fragment was found inserted into B. subtilis 149. This protein function has not been introduced or studied. Therefore, through the analysis of the physical and chemical properties of the polypeptide, Lc149 was a novel amphiphilic, α-helix, and anionic AMP. Related studies have shown that the antibacterial peptides with more an α-helix structure, more positive charge, and stronger hydrophobicity have stronger antibacterial activity [19,20,21]. α-helical AMPs are the most abundant AMPs in nature and have been isolated from many species. The first discovered fish AMP is pardaxin, an α-spiral pardaxin isolated from the skin glands of Pardachirus marmoratus, which can form pores in the cell membrane [22]. The quantity of anionic antimicrobial peptides is relatively small. Daptomycin, an anionic AMP approved by the Food and Drug Administration (FDA) in 2020, can be used to treat skin problems such as skin infections caused by Staphylococcus aureus [23,24]. Dermcidin, an amphiphilic anionic AMP only expressed in human skin, forms ion channels by binding to the phospholipid bilayer of bacteria to kill harmful bacteria like E. coli, S. aureus, and Candida albicans [25,26]. Maximin H5, isolated from the brain and skin of toads, is an anionic AMP with narrow-spectrum anti-bacterial activity, only against S. aureus [27]. Overall, anionic AMPs complement cationic AMPs.
In order to further analyze the bactericidal mechanism of rLc149 against E. coli and V. harveyi., the ability of rLc149 to destroy the integrity and permeability of the bacterial cell membrane, as well as the damage of bacterial DNA and protein, was further studied. In a previous study, we discovered that a Ferritin H fragment can puncture the outer membrane of target bacteria [28]. Consistent with these results, Octominin, derived from Octopus minor, was observed to damage to cell membrane of E. coli [29]. Additionally, the antimicrobial activity of dermaseptins is reported to be facilitated by the interaction of amphipathic a-helix with membrane phospholipids, enabling cell infiltration and lysis. As the above experimental results show, rLc149 can destroy the morphology and structure of the two pathogens, and destroy the cell membrane. In addition, the study on the mode of action of rLc149 after entering bacterial cells found that rLc149 cannot bind to bacterial DNA, but it can inhibit the synthesis of bacterial proteins and then affect the life activities of bacteria, resulting in the death of the bacteria. It is known that some AMPs, such as buforin 2 [30] and indolicidin [31], can bind to DNA after translocating E. coli membranes. Pleurocidin, a 25-residue fish α-spiral antimicrobial peptide isolated from the skin mucosa of winter flounder Pseudopleuronectes americanu, exhibits broad-spectrum antibacterial activity and can inhibit bacterial DNA, RNA, and protein synthesis [32]. Human Proadrenomedullin N-terminal 20 peptide (PAMP) and its C-terminal 12-residue peptide, PAMP (9–20), have been shown to effectively bind bacterial DNA [32,33]. Proline-Rich Anti-microbial Peptides (PR-AMPs) [34] inhibit the binding of peptide chain lengthening factors, prevent the synthesis of polypeptide chains, and have a strong bactericidal effect on Gram-negative bacteria (such as E. coli).
The stability and non-toxicity of antimicrobial peptides are very important in practical production and application. This study found that rLc149 still has relatively stable antibacterial activity after high temperature and strong radiation treatment, and it still has antibacterial activity under extremely acidic and alkaline conditions and the influence of a variety of enzymes. In addition, rLc149 hardly produced hemolysis in the blood cells of fish, shrimp, and rabbits, and had no obvious toxicity to LYCPCK cells and 293T cells. AMPs can not only have a lethal effect on pathogens but can also target host cells in high concentrations. Melittin, a 26 amino acid peptide, the major component of bee venom, can inhibit the multiplication of Chlamydia trachomatis, but is highly toxic to host cells [35]. Although natural melitoxin has certain toxicity, its derived antimicrobial peptides have retained a strong antibacterial effect through genetic engineering, while greatly reducing the toxicity to mammalian cells [36,37]. Nisin has been shown to have good biocompatibility in human and animal tests, with very low toxicity to normal cells, and is a safe antibacterial alternative [38].
The results indicate that the antibacterial activity of rLc149 may be achieved through the following mechanisms: initially altering the permeability of the bacterial cell membrane, then disrupting its structure upon entry, and inhibiting the synthesis and processing of bacterial proteins. These actions collectively suppress bacterial growth, ultimately leading to a bactericidal effect. In conclusion, rLc149 is a relatively stable and safe antibacterial agent with significant potential for application in practical production.
5. Conclusions
In this study, rLc149 exhibited killing effects on E. coli and V. harveyi. rLc149 caused bacterial death through induced irregular shape changes, cytoplasm agglutination, and destruction of the bacterial cell membrane, altering membrane permeability. Furthermore, rLc149 induced a decrease in bacterial protein content. After treatment with different temperatures, acid–base conditions, ultraviolet radiation, and various proteases, rLc149 still maintained its antibacterial activity against E. coli and V. harveyi. In addition, rLc149 demonstrated good biosafety and low hemolytic and cytotoxicity levels. Therefore, rLc149 can serve as a promising development object for antimicrobial agents in the future, with potential for application in food, aquaculture, and medical fields.
Author Contributions
Methodology, validation, and writing the original manuscript, C.Y.; Investigation, collected samples, and data analysis, M.C. and H.X.; Reviewed paper, J.J., X.L. and Z.W.; Supervised the work and revised the manuscript, D.Z. All authors have read and agreed to the published version of the manuscript.
Funding
This work was supported by grants from the National Natural Science Foundation of China (32172964), key projects of the Fujian Provincial Natural Science Foundation (2022J02042), and Xiamen science and technology subsidy project (2024CXY0320).
Institutional Review Board Statement
Specimen collection and anatomical observation were conducted in accordance with the protocol approved by Animal Care and Use Committee at the College of Aquaculture, Jimei University (Number: Jmu20240830).
Informed Consent Statement
Not applicable.
Data Availability Statement
All data generated or analyzed in this study are included in published articles and are obtained from the respective authors at reasonable request.
Conflicts of Interest
The authors declare that they have no known competing financial interests or personal relationships that could have appeared to influence the work reported in this paper.
References
- Malik, H.; Singh, R.; Kaur, S.; Dhaka, P.; Bedi, J.S.; Gill, J.P.S.; Gongal, G. Review of antibiotic use and resistance in food animal production in WHO south-east asia region. J. Infect. Public Health 2023, 16, 172–182. [Google Scholar] [CrossRef] [PubMed]
- Naylor, R.L.; Hardy, R.W.; Buschmann, A.H.; Bush, S.R.; Cao, L.; Klinger, D.H.; Little, D.C.; Lubchenco, J.; Shumway, S.E.; Troell, M. Publisher correction: A 20-year retrospective review of global aquaculture. Nature 2021, 595, E36. [Google Scholar] [CrossRef] [PubMed]
- Wang, C.; Li, Z.; Wang, T.; Xu, X.; Zhang, X.; Li, D. Intelligent fish farm-the future of aquaculture. Aquac. Int. 2021, 29, 2681–2711. [Google Scholar] [CrossRef] [PubMed]
- Schar, D.; Klein, E.Y.; Laxminarayan, R.; Gilbert, M.; Van Boeckel, T.P. Global trends in antimicrobial use in aquaculture. Sci. Rep. 2020, 10, 21878. [Google Scholar] [CrossRef] [PubMed]
- Xu, Y.; Krafft, T.; Martens, P. The interaction between climate change and marine fisheries: Review, challenges, and gaps. Ocean Coast. Manag. 2024, 259, 107479. [Google Scholar] [CrossRef]
- Yadav, N.K.; Patel, A.B.; Singh, S.K.; Mehta, N.K.; Anand, V.; Lal, J.; Dekari, D.; Devi, N.C. Climate change effects on aquaculture production and its sustainable management through climate-resilient adaptation strategies: A review. Environ. Sci. Pollut. Res. 2024, 31, 31731–31751. [Google Scholar] [CrossRef] [PubMed]
- Xu, S.; Ge, M.; Feng, J.; Wei, X.; Tan, H.; Liang, Z.; Tong, G. Epidemiological investigation on diseases of larimichthys crocea in ningbo culture area. Front. Cell. Infect. Microbiol. 2024, 14, 1420995. [Google Scholar] [CrossRef] [PubMed]
- Gallardo Lagno, A.; Lara, M.; Cornejo, J. Aquatic animal health: History, present and future. Rev. Sci. Tech. 2024, Special Edition, 152–158. [Google Scholar] [CrossRef] [PubMed]
- Bateman, K.S.; Paley, R.K.; Batista, F.M.; Bass, D.; Peeler, E.J. Advances in aquatic animal health within the framework of the world organisation for animal health. Rev. Sci. Tech. 2024, 159–167, Special Edition. [Google Scholar] [CrossRef] [PubMed]
- Erdem Büyükkiraz, M.; Kesmen, Z. Antimicrobial peptides (AMPs): A promising class of antimicrobial compounds. J. Appl. Microbiol. 2022, 132, 1573–1596. [Google Scholar] [CrossRef] [PubMed]
- Ji, S.; An, F.; Zhang, T.; Lou, M.; Guo, J.; Liu, K.; Zhu, Y.; Wu, J.; Wu, R. Antimicrobial peptides: An alternative to traditional antibiotics. Eur. J. Med. Chem. 2024, 265, 116072. [Google Scholar] [CrossRef] [PubMed]
- Luo, Y.; Song, Y. Mechanism of antimicrobial peptides: Antimicrobial, anti-inflammatory and antibiofilm activities. Int. J. Mol. Sci. 2021, 22, 11401. [Google Scholar] [CrossRef] [PubMed]
- Souza, C.C.D.; Guimarães, J.M.; Pereira, S.D.S.; Mariúba, L.A.M. The multifunctionality of expression systems in bacillus subtilis: Emerging devices for the production of recombinant proteins. Exp. Biol. Med. 2021, 246, 2443–2453. [Google Scholar] [CrossRef] [PubMed]
- Liu, Y.; Liu, L.; Li, J.; Du, G.; Chen, J. Synthetic biology toolbox and chassis development in bacillus subtilis. Trends. Biotechnol. 2019, 37, 548–562. [Google Scholar] [CrossRef] [PubMed]
- Kang, Q.; Xiang, M.; Zhang, D. [Research progress and industrial application of bacillus subtilis in systematic and synthetic biotechnology]. Sheng Wu Gong Cheng Xue Bao Chin. J. Biotechnol. 2021, 37, 923–938. [Google Scholar]
- Cui, W.; Han, L.; Suo, F.; Liu, Z.; Zhou, L.; Zhou, Z. Exploitation of bacillus subtilis as a robust workhorse for production of heterologous proteins and beyond. World J. Microbiol. Biotechnol. 2018, 34, 145. [Google Scholar] [CrossRef] [PubMed]
- Chen, M.; Xiao, Z.; Yan, C.; Tang, X.; Fang, M.; Wang, Z.; Zhang, D. Centrosomal protein of 192 kda (cep192) fragment possesses bactericidal and parasiticidal activities in larimichthys crocea. Int. J. Biol. Macromol. 2024, 254, 127744. [Google Scholar] [CrossRef] [PubMed]
- Folgueira, I.; Lamas, J.; Sueiro, R.A.; Leiro, J.M. Molecular characterization and gene expression modulation of the alternative oxidase in a scuticociliate parasite by hypoxia and mitochondrial respiration inhibitors. Sci. Rep. 2020, 10, 11880. [Google Scholar] [CrossRef] [PubMed]
- Santana, P.A.; Salinas, N.; Álvarez, C.A.; Mercado, L.A.; Guzmán, F. Alpha-helical domain from IL-8 of salmonids: Mechanism of action and identification of a novel antimicrobial function. Biochem. Biophys. Res. Commun. 2018, 498, 803–809. [Google Scholar] [CrossRef]
- Acosta, J.; Carpio, Y.; Valdés, I.; Velázquez, J.; Zamora, Y.; Morales, R.; Morales, A.; Rodríguez, E.; Estrada, M.P. Co-administration of tilapia alpha-helical antimicrobial peptides with subunit antigens boost immunogenicity in mice and tilapia (oreochromis niloticus). Vaccine 2014, 32, 223–229. [Google Scholar] [CrossRef] [PubMed]
- Loffredo, M.R.; Casciaro, B.; Bellavita, R.; Troiano, C.; Brancaccio, D.; Cappiello, F.; Merlino, F.; Galdiero, S.; Fabrizi, G.; Grieco, P.; et al. Strategic single-residue substitution in the antimicrobial peptide esc (1-21) confers activity against staphylococcus aureus, including drug-resistant and biofilm phenotype. ACS Infect. Dis. 2024, 10, 2403–2418. [Google Scholar] [CrossRef] [PubMed]
- Wong, Y.H.; Wong, S.R.; Lee, S.H. The therapeutic anticancer potential of marine-derived bioactive peptides: A highlight on pardaxin. Int. J. Pept. Res. Ther. 2023, 29, 90. [Google Scholar] [CrossRef]
- Pokorny, A.; Almeida, P.F. The antibiotic peptide daptomycin functions by reorganizing the membrane. The Journal of Membrane Biology 2021, 254, 97–108. [Google Scholar] [CrossRef] [PubMed]
- Huang, H.W. DAPTOMYCIN, its membrane-active mechanism vs. That of other antimicrobial peptides. Biochimica Biophysica Acta. Biomembranes 2020, 1862, 183395. [Google Scholar] [CrossRef] [PubMed]
- Schittek, B.; Hipfel, R.; Sauer, B.; Bauer, J.; Kalbacher, H.; Stevanovic, S.; Schirle, M.; Schroeder, K.; Blin, N.; Meier, F.; et al. Dermcidin: A novel human antibiotic peptide secreted by sweat glands. Nat. Immunol. 2001, 2, 1133–1137. [Google Scholar] [CrossRef] [PubMed]
- Rieg, S.; Seeber, S.; Steffen, H.; Humeny, A.; Kalbacher, H.; Stevanovic, S.; Kimura, A.; Garbe, C.; Schittek, B. Generation of multiple stable dermcidin-derived antimicrobial peptides in sweat of different body sites. J. Investig. Dermatol. 2006, 126, 354–365. [Google Scholar] [CrossRef] [PubMed]
- Lai, R.; Liu, H.; Hui Lee, W.; Zhang, Y. An anionic antimicrobial peptide from toad bombina maxima. Biochem. Biophys. Res. Commun. 2002, 295, 796–799. [Google Scholar] [CrossRef] [PubMed]
- Chen, M.; Lin, N.; Liu, X.; Tang, X.; Wang, Z.; Zhang, D. A novel antimicrobial peptide screened by a bacillus subtilis expression system, derived from larimichthys crocea ferritin h, exerting bactericidal and parasiticidal activities. Front. Immunol. 2023, 14, 1168517. [Google Scholar] [CrossRef] [PubMed]
- Nikapitiya, C.; Dananjaya, S.H.S.; Chandrarathna, H.P.S.U.; De Zoysa, M.; Whang, I. Octominin: A novel synthetic anticandidal peptide derived from defense protein of octopus minor. Mar. Drugs 2020, 18, 56. [Google Scholar] [CrossRef] [PubMed]
- Khodam Hazrati, M.; Vácha, R. Membrane adsorption enhances translocation of antimicrobial peptide buforin 2. J. Phys. Chem. B 2024, 128, 8469–8476. [Google Scholar] [CrossRef] [PubMed]
- Smirnova, M.P.; Kolodkin, N.I.; Kolobov, A.A.; Afonin, V.G.; Afonina, I.V.; Stefanenko, L.I.; Shpen’, V.M.; Shamova, O.V.; Kolobov, A.A. Indolicidin analogs with broad-spectrum antimicrobial activity and low hemolytic activity. Peptides 2020, 132, 170356. [Google Scholar] [CrossRef] [PubMed]
- Ko, S.J.; Kang, N.H.; Kim, M.K.; Park, J.; Park, E.; Park, G.H.; Kang, T.W.; Na, D.E.; Park, J.B.; Yi, Y.E.; et al. Antibacterial and anti-biofilm activity, and mechanism of action of pleurocidin against drug resistant staphylococcus aureus. Microb. Pathog. 2019, 127, 70–78. [Google Scholar] [CrossRef] [PubMed]
- Ajish, C.; Yang, S.; Kumar, S.D.; Shin, S.Y. Proadrenomedullin n-terminal 20 peptide (PAMP) and its c-terminal 12-residue peptide, PAMP(9-20): Cell selectivity and antimicrobial mechanism. Biochem. Biophys. Res. Commun. 2020, 527, 744–750. [Google Scholar] [CrossRef] [PubMed]
- Imjongjirak, C.; Amphaiphan, P.; Charoensapsri, W.; Amparyup, P. Characterization and antimicrobial evaluation of SpPR-AMP1, a proline-rich antimicrobial peptide from the mud crab scylla paramamosain. Dev. Comp. Immunol. 2017, 74, 209–216. [Google Scholar] [CrossRef] [PubMed]
- Chen, J.; Guan, S.; Sun, W.; Fu, H. Melittin, the major pain-producing substance of bee venom. Neurosci. Bull. 2016, 32, 265–272. [Google Scholar] [CrossRef] [PubMed]
- Akbari, R.; Hakemi Vala, M.; Hashemi, A.; Aghazadeh, H.; Sabatier, J.; Pooshang Bagheri, K. Action mechanism of melittin-derived antimicrobial peptides, MDP1 and MDP2, de novo designed against multidrug resistant bacteria. Amino Acids 2018, 50, 1231–1243. [Google Scholar] [CrossRef] [PubMed]
- Bergaoui, I.; Zaïri, A.; Gharsallah, H.; Aouni, M.; Hammami, A.; Hani, K.; Selmi, B. The in vitro evaluation of anti-chlamydial and cytotoxic properties of dermaseptin s4 and derivatives: Peptides from amphibian skin. Med. Chem. Res. 2013, 22, 6096–6104. [Google Scholar] [CrossRef]
- Shin, J.M.; Gwak, J.W.; Kamarajan, P.; Fenno, J.C.; Rickard, A.H.; Kapila, Y.L. Biomedical applications of nisin. J. Appl. Microbiol. 2016, 120, 1449–1465. [Google Scholar] [CrossRef] [PubMed]
Disclaimer/Publisher’s Note: The statements, opinions and data contained in all publications are solely those of the individual author(s) and contributor(s) and not of MDPI and/or the editor(s). MDPI and/or the editor(s) disclaim responsibility for any injury to people or property resulting from any ideas, methods, instructions or products referred to in the content. |
© 2025 by the authors. Licensee MDPI, Basel, Switzerland. This article is an open access article distributed under the terms and conditions of the Creative Commons Attribution (CC BY) license (https://creativecommons.org/licenses/by/4.0/).